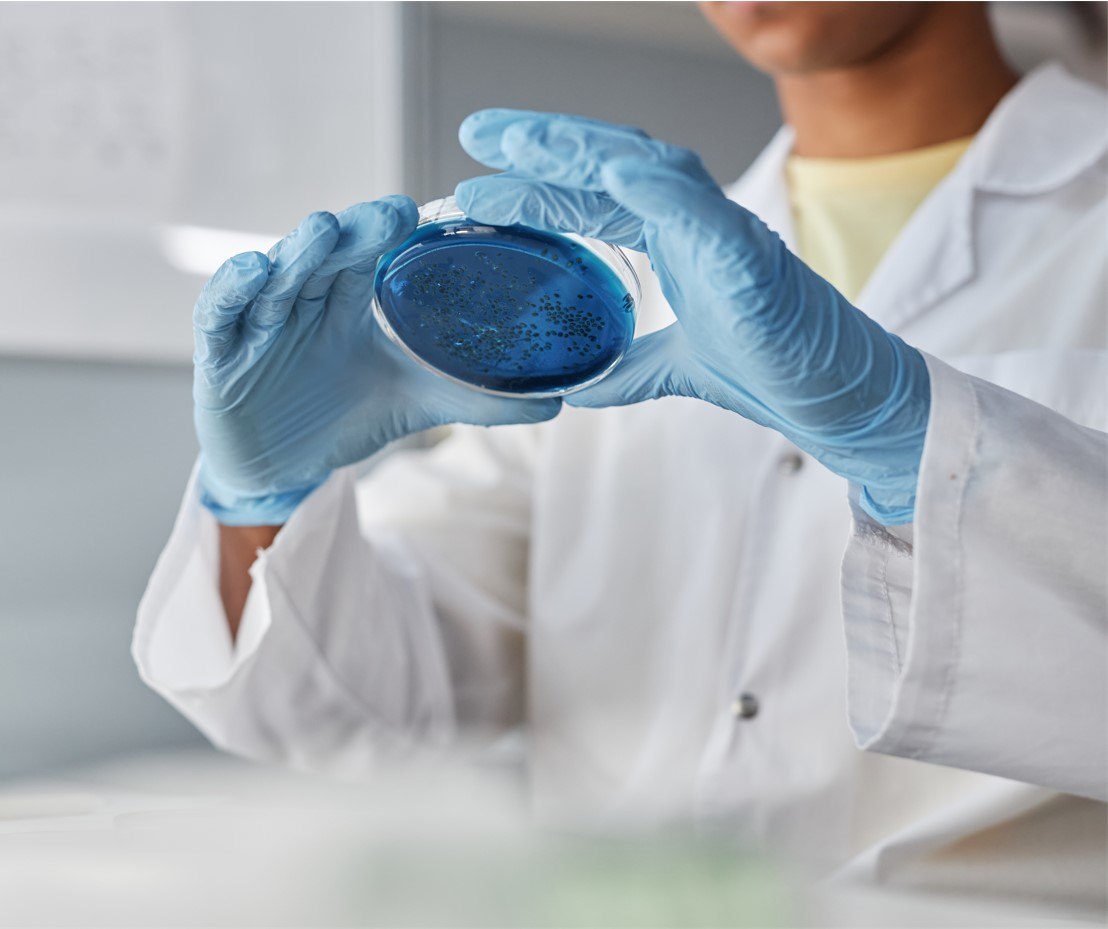

Save on beer testing and brewery supplies

Welcome to our curated selection of brewery essentials from ATP sanitation systems, pH meters, dissolve oxygen tests, micro testing media, plastic and glass supplies, to brewery-specific filter papers.
On tap at Weber:



Are the best prices for testing supplies only reserved for large labs or big breweries?
Our pricing is transparent for all to see. We don’t have a tiered system at Weber. Every customer gets a fair price for beer testing essentials.
Cheers to great beer and even greater savings!
Your time should be spent on fermentation, not frustration over supply backlogs and cost control.

Plus, if you need something unique, we're happy to source special-order items directly from our suppliers.
Don’t have time to browse? Chat with your dedicated account manager for a custom quote.
Brewery Essentials
Brewing Test Kits

Borosilicate glass Total Acidity and Bitterness Brewing Kit for USP Type I and ASTM E438 tests.
Orion Star A111 Benchtop pH Meters

Benchtop pH meter with up to 3 point pH calibration and automatic recognition for USA/NIST and DIN buffers
Orion Star PH111 pH/mV Meters

Benchtop meter to measure pH or ORP simultaneously with mV and temperature
Aroxa Beer Flavor Standard Kits

Sensory training kits to train professional beer tasters to recognize and scale the intensity of ten different beer flavor notes.
Sanitation Validation
EnSURE Touch

Advanced monitoring system that collects, analyzes and reports data with a 5-inch touch screen, wireless sync technology, and cloud-based software.
UltraSnap

High sensitivity, cost-effective, all-in-one test. Detects 0.1 femtomoles of ATP. Compatible with EnSURE Touch and EnSURE Luminometer.
SuperSnap

The most sensitive ATP test: four times more sensitive than UltraSnap. Compatible with EnSURE Touch and EnSURE Luminometer.
AquaSnap

Detects free ATP in solution and microbial ATP. Analyze water quality in 15 sec. Compatible with EnSURE Touch and EnSURE luminometer.
Alconox Precision Cleaner

Biodegradable, odorless, colorless and mild (pH 9-9.5) cleaning powder for manual use in hot or cold and hard or soft water.
Tergazyme Detergent

Concentrated, biodegradable powdered detergent to pass cleaning validation tests for lab accreditation and plant inspection approval.
Alcojet Dishwasher Powder

Detergent powder with lubricating formula to protect the metal parts of mechanical washers.
Allergen Test
Dehydrated Media
Bacteriological Agar

General-purpose medium used for cultivating a wide range of bacteria and yeasts for screening for various types of microbial contaminants in breweries.
Universal Beer Agar

Universal Beer Agar is a growth medium particularly tailored to breweries to check for microbial contaminants in wort and beer.
Barney Miller Agar

Developed by the Miller Brewing Company to detect lactic acid bacteria in the brewing process.
WL Nutrient Agar

Wallerstein Laboratories Nutrient Agar for cultivating yeasts, molds, and bacteria in brewing.
WLD

Wallerstein Labs Differential Medium to detect beer spoilage Lactobacillus spp. and Pediococcus spp.
LMDA

ASBC conformed Lee's Multi Differential Agar or Schwarz Differential Agar (SDA) Medium to detect multiple beer spoilage organisms.
HLP

Hsu's Lactobacillus and Pediococcus media isolates and monitors Hop resistant Lactobacillus and Pediococcus bacteria at various stages of production.
LWYM

Lin's Wild Yeast Medium isolates wild yeast strains, which can introduce unwanted flavors or spoil a beer batch. Valuable quality control for the fermentation process.
LCSM

Lin's Cupric Sulfate Medium isolates and cultivates specific strains of bacteria and yeast that are inhibited by copper ions. Effective assessment to your brewery's sanitation and sterilization procedures.
Cycloheximide Crystals

Crystalline cyclohexamide (CHX) prevents the growth of brewers yeast in culture media.
Microbiological Testing
GasPak

The gold standard for the isolation and cultivation of anaerobic, microaerophilic or capnophilic bacteria.
NBB Prepared Culture Media

Ready-to-use media containing specific nutrients for the Lactobacilli, Pectinatus and Megasphaera.
Beer Spoilage PCR Micro Test Kit

Simultaneous detects 6 spoilage organisms in one test, results within 2 hours: wild yeasts (Saccharomyces diastaticus, Brettanomyces) and bacteria (hops-resistant Lactic acid bacteria, Acetic acid bacteria, Megasphaera and Pectinatus).
DB Pre-filled Dilution Bottles and Tubes

Butterfield’s Buffer and Phosphate Buffer in sterilized PET bottles or tubes. Available pre-filled volume: 90ml or 99ml bottles and 9ml tubes.
Deionized Water

Compliant to Standard Methods for the Examination of Water and Wastewater, 21st edition, 9020:II Quality of Reagent Water Used in Microbiology Testing
Portable Thermal Cycler

4-well heating block and heating lid with programmable temperature between 30°C – 105°C, for cost-effective PCR testing.
Water Testing
BrewLab Water Analysis Kits

7 factors BrewLab Basic Kit and BrewLab Plus pH Kit to quantifying water test
Dissolved Oxygen Pen

EPA-approved, waterproof DO metering pen to determine water quality.
Orion Star DO Meter Kit

Waterproof, rugged dissolved oxygen meter for advanced field analysis.
Colilert 18 and Colisure

EPA approved coliforms and E. coli testing for water. Conclusive results in 18 hours.
Equipment
Portable Sterilizer

Autometic, self-contained sterilizer. Complete sterilization process in 20-30 min.
Ductless Filtering Fume Hood

Filters toxic gases, fumes, odors, and powders. Includes automatic filter breakthrough alarm.
Ductless Laminar Flow Hoods

Provides an ISO Class 5 work environment with HEPA H14 filters.
Lab Incubator

Ambient to 60°C compact incubators, available in digital and analog models.
Brightfield Compound Microscope

Afforable, lab quality microscope with ultra-low position stage controls and halogen illumination.
Hot Plates

5” x 5” or 7”x 7” hot plates with maximum heating temperature of 380°C or 550°C.
Hot Plate Stirrer

1500 rpm magnetic stirrer with 5” x 5” or 7”x 7” hot plates with maximum heating temperature of 380°C or 550°C.
Vortex Mixer

Vortexing for tubes up to 50ml, with a 4 mm orbit and fixed speed of 2800 rpm
Portable Scales

Affordable, energy efficient scales available in 220g, 2200g, and 5200g capacities.
Butane Laboratory Burner

Delivers temperatures up to 3000°F for up to 5.5 hours from a single disposable butane fuel container.
Personal Mini Centrifuge

6,000 rpm palm-size centrifuge with eight position micro tube rotor.
Beer Testing Filter Papers
Filter Papers

Ashless, cotton fiber, glass microfiber, pleated, and standard filter papers in various grades.
Sampling & Testing Supplies
Disposable Nitrile Gloves

Powder-free, food grade, 5 mil, elbow-length gloves with micro-textured fingers.
Sterile Petri Dishes

Medical-grade virgin polystyrene, disposable Petri dishes in various sizes.
Loops and Spreaders

Inoculating loops and cell spreaders made from sterile plastic and autoclavable aluminum.
Plastic and Glass Labware

Flasks, cylinders, culture tubes, beakers, etc. for your testing needs
Biosart Sterile Monitor

Sterile, disposable monitors with a 0.45 µm membrane filter and cellulose pad.
Syringe Filters

For liquids, air, and gasses clarification, sterile or non-sterile filtration, sample preparation, and sterile or non-sterile venting.
Pipettors & Tips

Affordable pipettors, tips, racks, everything for your liquid handling needs.
Gram Stain Kit

8 oz. (250 mL) flip-top bottle each of 1% Crystal Violet, Gram’s Iodine, 0.4% Safranin, 25% Acetone/Alcohol.
pH Buffer Solution

Color-coded, 500 ml size packaged pH buffers in polyethylene bottle with flip-top dispensing cap.
Reagent Grade Isopropyl Alcohol

2-Propanol, available in gallon-size ACS Grade. 99% purity laboratory chemical for analyses and disinfection purposes.
Need help finding a product, placing a standing order, or anything else?
Let's get you connected!
Complete the form below with your question and your Weber Scientific sales rep will get back to you within 24 hours.